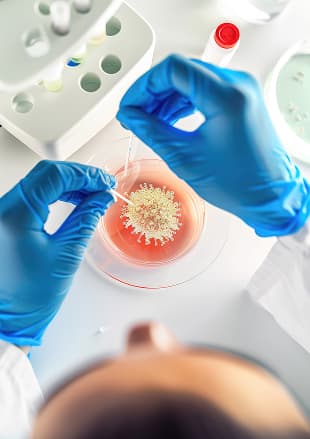
Targeted therapy and immunotherapy

Our Medical and Surgical Oncology Department provides comprehensive care for patients with cancer.
The department manages cancer treatment using both medical and surgical approaches. Medical oncology includes chemotherapy, targeted therapy, and supportive care to manage symptoms and improve outcomes. Surgical oncology focuses on tumor removal and reconstructive procedures when necessary.
Each patient undergoes a thorough evaluation to determine the best treatment plan. Imaging, lab tests, and multidisciplinary consultations guide the approach. Care is coordinated across specialties to ensure safe, effective, and timely interventions.
Support services, including counseling, nutrition guidance, and rehabilitation, are offered to patients and families. Education is provided on treatment options, side effects, and self-care strategies. The goal is to provide holistic care that addresses both medical and emotional needs.
The department also emphasizes early detection and preventive care whenever possible. Patients are guided on recognizing warning signs, understanding risk factors, and attending regular screenings. This proactive approach helps identify problems at an early stage, allowing for timely intervention and better outcomes. Families are included in discussions to provide support and ensure that patients feel informed and empowered throughout their treatment journey.
What treatments are available in Oncology?
+Is the care multidisciplinary?
+Are support services available?
+How is follow-up care handled?
+